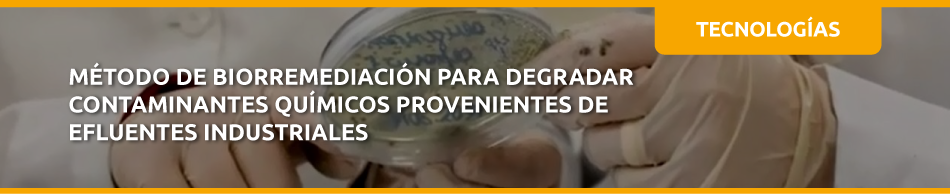

Propiedad Intelectual – Patente Concedida:
Estados Unidos: US11421435
Propiedad Intelectual – Patente en Fase Nacional:
Chile: CL2021001539
Tecnología desarrollada
La tecnología consiste en un dispositivo que aísla a las edificaciones de los movimientos provocados por los sismos, reduciéndolos hasta en un 90% y no pierde estabilidad debido al peso del edificio conforme éste va ganando altura. Esto permite que pueda ser utilizado en edificios de altura hasta 6 veces superior a su base (6:1), sin tener el riesgo de poder llegar a volcarse.
Beneficios / Ventajas
• Reduce hasta un 90% (10 a 1) la sensación del sismo de los ocupantes de un edificio, lo que aumentaría la sensación de seguridad de los ocupantes.
• Facilidad de uso, utiliza la misma forma de anclaje que la utilizada en la actualidad con otros dispositivos aisladores sísmicos, no siendo necesario un anclaje especial.
• Posibilita aislar sísmicamente edificios de esbeltez 6:1 o superior, sin el riesgo de que el aislador pueda inducir su volcamiento.
• Protege a los ocupantes, estructura y contenido de los edificios de los efectos del sismo.
• Aumenta el valor agregado de los edificios por concepto de seguridad.
• Creación de una imagen de “construcciones seguras” para la empresa constructora o inmobiliaria lo que aportaría valor a la marca comercial de este tipo de empresas.
Usos / Aplicaciones
Consiste en un dispositivo aislador sísmico que se instala entre las fundaciones y la estructura del edificio, protegiendo de esta manera a los ocupantes, estructura y contenido de la edificación. El dispositivo puede ser utilizado en la industria de la construcción, inmobiliaria o empresas con grandes edificaciones.
Oferta tecnológica
La tecnología está disponible para licenciamiento.
Estado de desarrollo
TRL 5, ya que se cuenta con pruebas a nivel experimental y validación del sistema integrado en una estructura de rack de almacenamiento industrial, en entorno de laboratorio y con sismo simulado.
Investigador principal
Dr. Nelson Maureira, Facultad de Ingeniería.